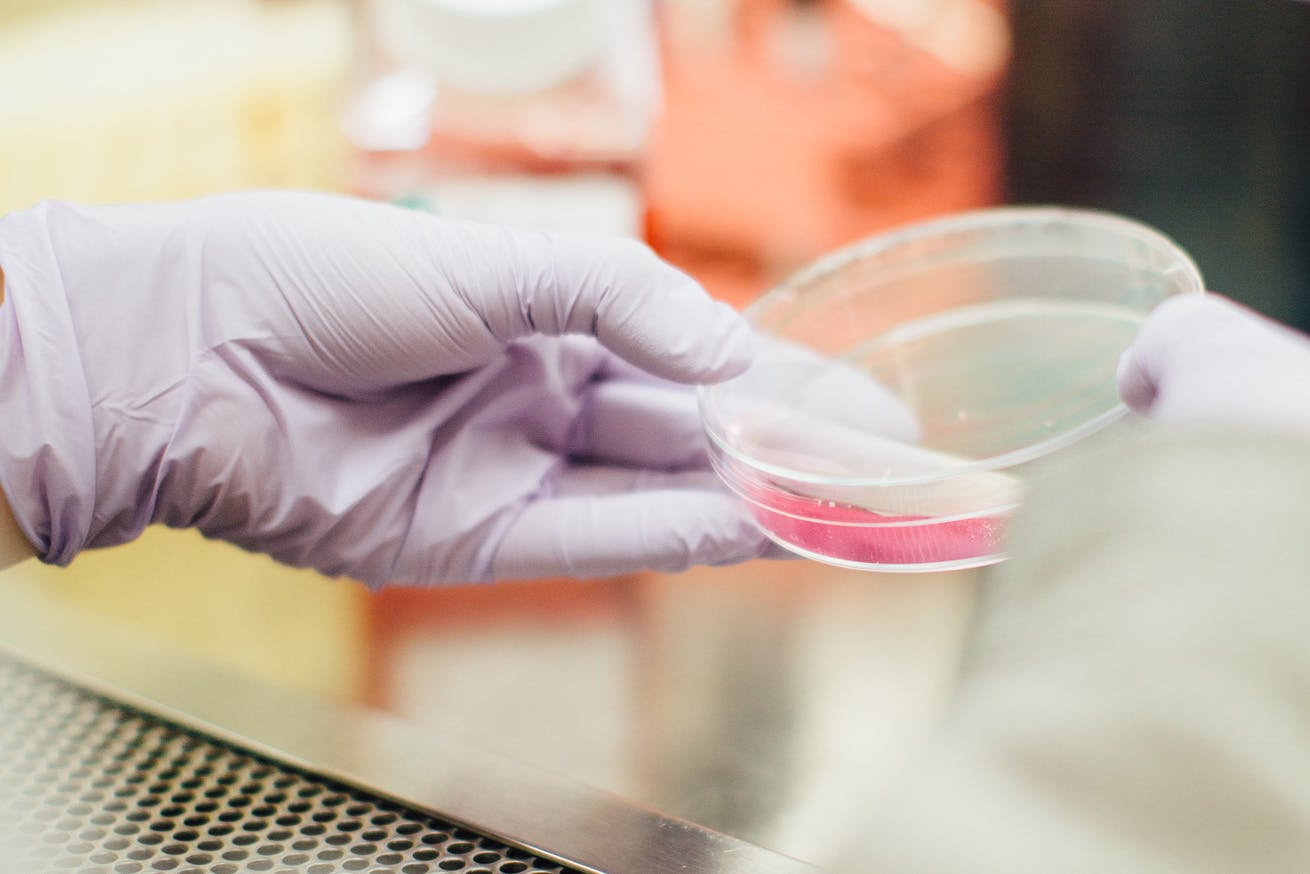

Barrett's Oesophagus
Barrett's Oesophagus and its relation to reflux disease
Enquire about Barrett's Oesophagus
Barrett's Oesophagus
Barrett’s Oesophagus is named after a famous British surgeon, Norman Barrett. It describes a condition associated with Reflux Disease in which the normal cells lining the bottom of the oesophagus are replaced by abnormal cells. In turn, these ‘abnormal’ cells are associated with an increased risk of developing oesophageal cancer.
The precise number of people in the general population with Barrett’s isn’t known. However, 20-30% of the adult population have reflux disease (GORD) and of these 5-10% will have Barrett’s. Of all those people referred for an endoscopy by their GP studies suggest that as many as 1 in 5 will be diagnosed with Barrett’s.
Naturally, these are concerning figures and the risk means that it is of paramount importance that those who have suffered with reflux symptoms over a long period of time undergo a gastroscopy to observe any cell damage this may have done.
To explain Barrett’s Oesophagus requires that we get rather technical, hence this being a long and detailed page. It is such an important subject, and of concern to so many people we meet in clinic, that we have decided to provide a very comprehensive guide. We’ve tried to write it in such a way that it is easy to follow but if you have any questions, please call or email us and we will reply to you personally.
About 6 years ago, a small ulcerative lesion was found in the distal oesophagus and Barrett's oesophagus was diagnosed
The Oesophagus
The oesophagus is a muscular tube which passes from the throat, through the chest cavity behind the heart, and then into the stomach where the digestive process starts. The cells of the lining of the oesophagus are called mucosa which are specific to this area of the body. In the oesophagus, these cells protect the underlying muscle layer and are flat, pale and orientated in layers, very much like those in the skin. This is called the stratified epithelium.
In the stomach, the mucosa has many other functions including secreting mucous, acid and enzymes. The cells are arranged differently; being more square, red in colour and organised as “columns”. This is called columnar epithelium.
Observing Barrett's Oesophagus
In Barrett’s Oesophagus, the cells at the bottom of the oesophagus change from the stratified type to resemble columnar epithelium. The appearance therefore changes from a pale colour to red “salmon pink” and is sometimes called “columnar-lined oesophagus”.
Barrett’s is also known as “columnar metaplasia”. Metaplasia is a condition in which one adult cell replaces another. In Barrett’s Oesophagus, columnar cells replace stratified cells, hence columnar metaplasia.
Strictly speaking Barrett’s is divided into “long segment” and “short segment” disease. If the abnormal cells extend no more than 3cm from the top of the stomach this is defined as short segment and if 3cm or more, long segment. This distinction helps doctors stratify risk, as the longer the segment of Barrett’s the more abnormal cells it will contain and the more likely it may progress to cancer. Short segment is about three times as common as long segment Barrett’s.

What causes Barrett's Oesophagus?
Barrett’s is caused by the repeated inflammation of the oesophagus that arises from reflux disease (GERD).
Normally, the valve mechanism at the bottom of the oesophagus, known as the lower oesophageal sphincter (LOS), prevents excessive reflux of acid and other stomach contents into the oesophagus. When this valve fails, the cells lining the bottom of the oesophagus are exposed to the contents are usually kept within the stomach. This can cause inflammation and in response to repeated episodes of inflammation the cells change (undergoing metaplasia) from stratified to columnar epithelium.
Both GORD and Barrett’s can run in families but there is currently no specific genetic test that can predict outcome.
Barrett’s is also associated with obesity, especially in middle aged, caucasian men, and smoking.
Its worth noting that some patients who develop Barrett’s often do not suffer typical reflux symptoms and so are only diagnosed with Barrett’s when they start to experience symptoms from other conditions, including oesophageal cancer.
Changing Symptoms
Its also worth noting that very often symptoms of reflux actually improve as Barrett’s develops. This does not indicate that reflux has resolved or that there is no longer inflammation occurring, but probably reflects a change in nervous perception of the symptoms caused by reflux.
Is Barrett's Oesophagus dangerous?
Once patients are given the diagnosis of Barrett’s, its quite usual that they become very concerned. This is because Barrett’s can be a pre-malignant condition. The most common type of oesophageal cancer in the UK and Europe occurs at the junction of the stomach and oesophagus and is associated with Barrett’s Oesophagus. Known as adenocarcinoma, this type of cancer has been one of the fastest growing malignancies in terms of numbers of people diagnosed for over 30 years. However, it’s important to remember that while Barrett’s is common, oesophageal cancer is rare and most people with Barrett’s will not develop cancer.
There are many confusing terms associated with Barrett’s and its stepwise development to cancer. Barrett’s itself is otherwise known as “columnar metaplasia” because the normal cells lining the bottom of the oesophagus have changed, or undergone metaplasia from stratified to columnar epithelium. This lining is also known as the mucosa. In response to repeated inflammation these cells can then change further, a process called “dysplasia” which describes the development of abnormal tissue. In fact, dysplasia is further divided according to severity into “low grade” and “high grade”. This signifies a significant increase in risk of the cells progressing to the final step on the path to the development of cancer (carcinoma), “neoplasia”, or new tissue. Again, there are effectively two stages in the development of carcinoma. In the first the cancerous cells are confined to the mucosa. This is called intra-mucosal (or sometimes intra-epithelial) carcinoma. The final step in the development of cancer is when the cells spread through the other layers of the wall of the oesophagus and has therefore become invasive carcinoma.
So, Barrett’s is a pre-malignant condition and it undoubtedly confers an increased risk of developing adenocarcinoma of the oesophagus. The size of this risk remains in dispute but is probably between 30 and 125 times the normal population. Nonetheless, cancer of the oesophagus remains relatively uncommon and so most people diagnosed with Barrett’s will not progress to develop cancer. The size of the risk varies to some extent but overall it is about 0.5% per year and only one in twenty people with Barrett’s will develop cancer. Once dysplasia develops however the risk per year increases significantly. The risk of high grade dysplasia progressing to cancer is at least 10% per year.
More Frequently Asked Questions About Barrett’s Oesophagus
How is Barrett’s diagnosed?
Endoscopy
Barrett’s itself does not cause any specific symptoms. However, since it is caused by gastro-oesophageal reflux disease (GORD) it is usually diagnosed when patients undergo a gastroscopy (upper gastrointestinal endoscopy) as part of a series of tests into reflux type symptoms. The diagnosis is then made by the operator who will identify the characteristic appearance of dark “salmon red” columnar cells extending into the oesophagus above the stomach.
Biopsy
Having identified the appearances of Barrett’s biopsies will then be taken. These are tiny samples of tissue. Depending on the length of the segment multiple biopsies may be taken and these are then sent to the laboratory for analysis during which a pathologist will examine the tissue under a microscope. They will then be able to describe the typical abnormalities seen with Barrett’s and will also look for evidence of dysplasia or even cancer.
Capsule Sponge Test
This is a new technique which is still undergoing evaluation. A small capsule is swallowed which then expands into a sponge within about 5 minutes. This is attached to a string which is used by a nurse to withdraw the sponge through the oesophagus. During this process it collects cells lining the surface of the oesophagus. These are then tested for a specific protein (TFF3) which is expressed only by Barrett’s. If positive other tests can potentially be performed to look for genetic markers of dysplasia. You can read more about it here.
Should I have an endoscopy to check if I have Barrett's?
This is called “screening” and there is no evidence that this is justifiable in the general population. However, in patients with reflux symptoms and specific risk factors for the development of oesophageal cancer your specialist may offer an endoscopy.
If I have Barrett’s should I have a regular endoscopy?
Barrett’s is a pre-malignant condition and in a small number of patients will develop into cancer. This is the last stage in a progression through several stages during which the damage to the DNA in the cells at the bottom of the oesophagus gradually becomes more and more severe. Having been diagnosed with Barrett’s there is therefore an argument in favour of performing regular “surveillance” endoscopy with further biopsies to check for progression. There is evidence that this can identify changes at an early stage and improve survival.
However, exactly how often endoscopy should be performed will be dependent on several factors including the length of Barrett’s segment and the findings at previous endoscopy. Usually the interval between endoscopies will be 2-5 years but in some specific cases, for instance when dysplasia is identified, more frequently. You will need to discuss this with the specialist looking after you.
How is Barrett’s treated?
Uncomplicated Barrett’s
Unless dysplasia or cancer develops current evidence suggests that intervention is not indicated. In other words, the risks of removal of the Barrett’s cells are greater than the likely benefit and should therefore be avoided. However, your specialist will discuss the options for drug treatment and in particular the use of high dose Proton Pump Inhibitors (PPIS) and aspirin.
Complicated Barrett’s
Once dysplasia or cancer develops further treatment becomes necessary. The precise type of treatment will depend upon the nature of the abnormalities. and there are several options now available
- Photodynamic therapy (PDT): Abnormal cells in the Barrett’s segment are destroyed by light directed by laser. It has largely been replaced by radiofrequency ablation.
- Endoscopic radiofrequency ablation (RFA): A small coil is guided towards the abnormal section of oesophagus. This emits heat which destroys abnormal cells which are subsequently replaced by normal cells.
- Argon plasma coagulation: A jet of argon gas is directed at abnormal cells. An electric current is transmitted by the gas which then burns the cells.
- Endoscopic mucosal resection (EMR): Barrett’s cells, in the absence of invasive cancer, are confined to the layer of cells which lines the oesophagus (the mucosa). This can be lifted off the underlying muscle layers before being removed. The procedure is performed endoscopically using special instruments which enable resection of the abnormal tissue. Even early cancers can be removed using this technique, avoiding major surgery.
Should I take PPIs?
Barrett’s is caused by Gastro Oesophageal Reflux Disease (GORD). Reflux causes chronic inflammation at the bottom of the oesophagus and the major contributor to this is acid from the stomach. This is why antacid drugs are the mainstay of treatment for the symptoms caused by reflux. The most powerful antacid are PPIs (Proton Pump Inhibitors) such as Omeprazole and Nexium.
PPIs have now also been shown to confer a survival benefit in patients with Barrett’s. A big scientific study called the AspECT trial published in 2018 demonstrated that patients who took high doses of PPIs enjoyed a survival benefit over those who did not. There was a further benefit enjoyed if aspirin was added. However, PPIs are associated with other conditions and in particular with Small Intestinal Bacterial Overgrowth (SIBO) in which there is an abnormal colonisation of the gut by bacteria. Consequently, having been diagnosed with Barrett’s we would advise that you should discuss the benefits and risks treatment with your specialist.
Should I have an operation?
This is of course something which should be discussed with your specialist.